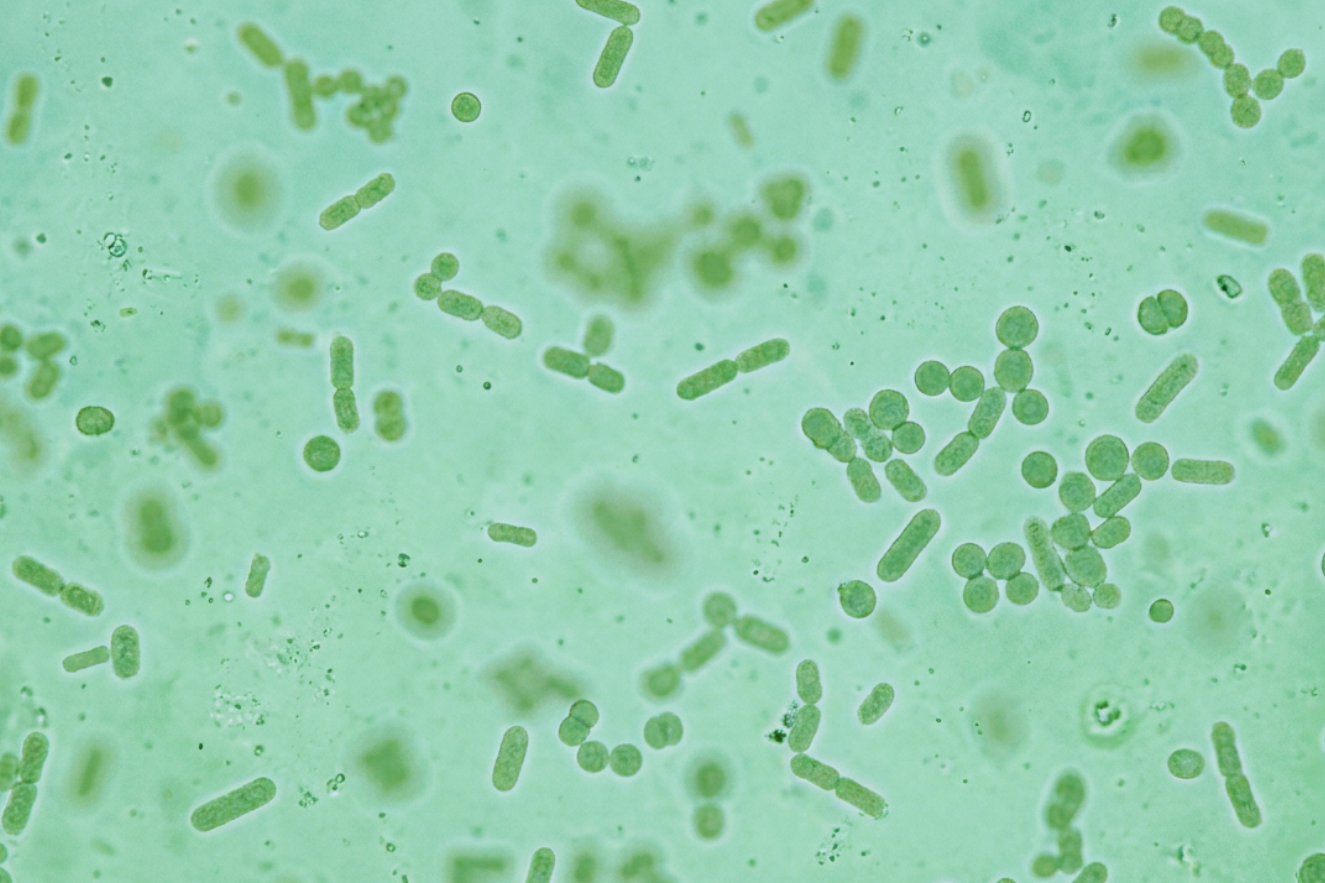
Türkiye

05.09.2017
Deterjanlar Ya Da Deterjanlarda Bulunan Yüzey Aktif Maddeler Kapsamında Değerlendirilen Ürünler İçin Teknik Dosya Ne Zaman Ve Neden Hazırlanır
31 Ekim 2013 tarih ve 28807 sayılı "Deterjanlar Ve Deterjanlarda Kullanılan Yüzey Aktif ...
Devamını Oku